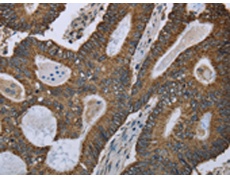
一抗

|
Background: |
Glutamic-oxaloacetic transaminase is a pyridoxal phosphate-dependent enzyme which exists in cytoplasmic and inner-membrane mitochondrial forms, GOT1 and GOT2, respectively. GOT plays a role in amino acid metabolism and the urea and tricarboxylic acid cycles. The two enzymes are homodimeric and show close homology. Two transcript variants encoding different isoforms have been found for this gene. |
|
Applications: |
ELISA, WB, IHC |
|
Name of antibody: |
GOT2 |
|
Immunogen: |
Fusion protein of human GOT2 |
|
Full name: |
glutamic-oxaloacetic transaminase 2, mitochondrial |
|
Synonyms: |
KAT4; KATIV; mitAAT |
|
SwissProt: |
P00505 |
|
ELISA Recommended dilution: |
2000-5000 |
|
IHC positive control: |
Human colon cancer and human liver cancer |
|
IHC Recommend dilution: |
100-300 |
|
WB Predicted band size: |
48 kDa |
|
WB Positive control: |
293T and Hela cells, Human fetal liver, mouse spleen and heart tissue, human fetal brain and hepatocellsular carcinoma tissue |
|
WB Recommended dilution: |
500-2000 |


 購物車
購物車 幫助
幫助
 021-54845833/15800441009
021-54845833/15800441009